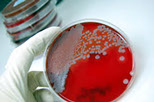

ООО "МИКРОБИОС" оборудование и тест-системы для микробиологии.
microBIOS
Тел: +7 (495) 532-80-35, e-mail: info@biomedsnab.ru
ООО "МИКРОБИОС" все права защищены 2014
Тел: +7 (495) 532-80-35, e-mail: info@biomedsnab.ru

ООО "МИКРОБИОС" оборудование и тест-системы для микробиологии.
microBIOS
Тел: +7 (495) 532-80-35, e-mail: info@biomedsnab.ru
ООО "МИКРОБИОС" все права защищены 2014
Тел: +7 (495) 532-80-35, e-mail: info@biomedsnab.ru